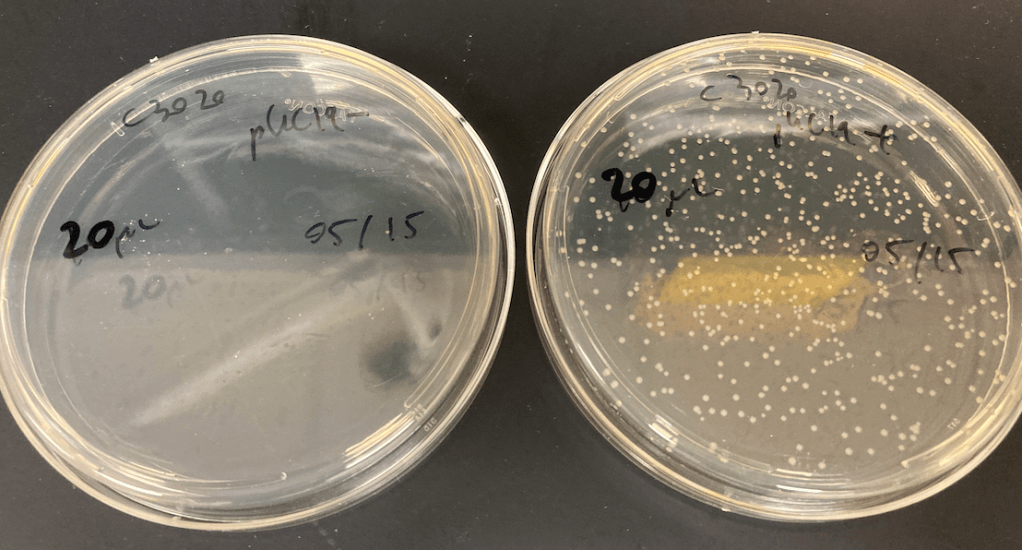

2025/04/28 – Our collaborative papers with the Allen Institute on using AAVs for in vivo multiplexing, and the surprising discovery of barcode swapping/chimerism in AAV packaging is now out in Nature Biotech and Nature Comms. Check out our brief report on BC swaps and Avery Hunker’s (Allen) comprehensive work on the difficulties of performing multiplexed MPRAs in mouse brains!
2025/04/23 – JB and Tony Li (long term collaborator) give presentations at the “Development, regulatory genomics, and AI” conference Stowers Institute. Lots of excitement at our use of model-guided and model-agnostic approaches to diversify enhancers, together with evolutionary angles to study the cis-element grammar! Preprints associated with both stories are now released (multi-scale deep dissection, evolutionary retracing and rewriting)!


2026/03/25 – The lab receives a big equipment order. We now have our own thermocyclers, biosafety cabinets, -80 freezer, multi-channel and more! We are extremely grateful to members of the department for kindly lending us some of their own equipment in our ramp up process (Serohijos, Ferbeyre, and Omichinski labs).




2026/01/30 – Kudos to Lorena and Zia present their work at the PREMIER undergraduate symposium at the MIL campus as posters discussing their quantitative exploration of the sequence-function relationship for transcriptional regulatory elements.


2026/01/29 – The lab’s proposal to study cis-regulatory elements along key developmental transitions in cancer progression is funded by the CIHR! Huge assist from Dr. Ali Jahanabad to wrap up our proposal at the end of summer 2025 and special thanks to our co-investigator Prof. G. Ferbeyre.

2026/01/16 – The lab celebrates the winter holidays and a successful first year with a fun activity with strong symbolism: archery. Our team of outstanding interns and JB aim for the bullseye. We unwillingly reproduced the textbook example of precision vs. accuracy, and Pierre-Olivier walks away with the much coveted golden pipette award!

2025/12/20 – Yani, Lorena, and Pierre-Olivier give fantastic summary presentations for their summer project. All three generated high-quality MPRA data on exciting projects. Congratulations!


2025/12/17 – JB gives a seminar at the Fragile Nucleosome Series. The video is available if you are curious to hear about our science directly. Topic covers our effort to dissect the sequence-function relationship for some select model developmental elements.

2025/11/11 – JB gives an outreach presentation about genomics at Marianopolis College. Thanks for the invite from the Student organizations there, the fun visit, and all the great questions!

2025/11/05-07 – JB participates to the first Genome Regulatory Code consortium meeting in Toronto. An amazing opportunity to brainstorm with leaders in the field about how to solve this exciting problem in genomics.

2025/11/03 – Dr. Najmeh Nikpour joins the lab. Coming from a postdoc at UBC, Najmeh has many years of experience working at the intersection of stem cells and regulatory functional genomics. In the lab, she will be characterizing developmental enhancers using saturation mutagenesis and single-cell techniques. Welcome Najmeh!
2025/10/30 – JB wins one of the Emergent Talent award from Genome Québec! It was a special honor to receive the award from medical genetics trailblazer Dr. Nada Jabado. We are most grateful for all the support from UdeM, the biochemistry department and the Institut Courtois d’Innovation Biomédicale. It would not be possible for us to do our research without everybody that keeps the Institute going.


2025/10/02 – The lab submits his first sequencing libraries to IRIC genomics core. Expert handling by the spectacular Dr. Raphaëlle Lambert leads to a successful run despite highly exotic read architecture combining multiple distinct libraries. QC scores fluctuated but we got >500M usable reads. Preliminary bioinformatic analysis confirm successful MPRA @ UdeM. Stay tuned!


2025/09/04 – The lab welcomes three new interns for the Fall of 2025. Shi Ping, Adam, and Ziad-Aïman. All three will be leveraging barcoding to study different aspects of gene regulation. Welcome!
2025/08/29 – We celebrate the end of summer and four outstanding internships with Yany, Pierre-Olivier, Zia, and Lorena. Everyone succeeded in generating different MPRA libraries!
2025/08/18 – Dr. Ali J. Jahanabad, who compiles over 15 years of experience in molecular biology, stem cell and functional genomics joins the lab as a research scientist. Welcome Ali!
2025/07/18 – The lab goes on its first mini-retreat, a half-day hike to nearby Mt Saint-Hilaire. A clear sunny day, spectacular summit views, and thoughtful discussions about the philosophy of science (and much more) makes this outing a success.



2025/06-07 Back-to-back in late June and mid-July, we were fortunate to welcome distinguished Shendurians Abby V. McGee and Dr. Troy A. McDiarmid for a UdeM lab tour. It is always fun connect with old friends!

2025/06/19 – JB connects with prior colleagues and friends on the beautiful UBC campus at Cascadia Advanced Genomics Technologies meeting and presents his forthcoming work on deep and multi-scale phenotyping of mammalian developmental CREs using barcoded assays.
2025/06/01 – The lab receives an solid score on its NSERC Discovery grant Quantitative multiscale profiling and modeling of mammalian transcriptional cis-regulatory epistasis. This will fund efforts to dissect fundamental aspects of enhancers’ sequence-to-function maps.

2025/05/23 – Stellar collaborator MD-PhD student Samuel G. Regalado teaming up with CX Qiu release two preprints one after the other respectively on lineage tracing and screening TF function in differentiation. JB contributed to experimental design/planning, sci experiments, and some computational analyses on this work illustrating both the power and challenges of performing functional genomics screens in stem-cell based differentiating systems. Congrats Sam and CX.
2025/05/16- JB gives a talk about the lab’s novel strategy, ‘regulatory derivatization’, to generate thousands of randomized enhancer variants that can display surprisingly high activity at 3e Symposium scientifique du Centre d’innovation biomédicale.
2025/05/15 – Cloning complex libraries is underway in PJAB. After multiple dielectric discharges with a legacy Gene Pulser, we can now electroporate at near 100% success. Many classes of reporters are being constructed, with millions of plasmids made. Impressive command of molecular biology techniques from our stellar interns Pierre-Olivier, Lorena, Yany, and Zia.

2025/05/05 – BCM summer interns Yani, Pierre-Olivier, Zia and Lorena start with projects leveraging barcoded enhancer assays to study regulatory sequence-function relationships. We celebrate their arrival with a Poulet Rouge lunch (thank you Pierre-Olivier for the suggestion!).
2025/05/02 – Huge day for the lab. JB completes his first-time ever PCR on Canadian soil. Success!
2025/04/30 – After a big spring clean up, the lab is ready for experiments!

2025/03/31 – An spotlight article on JB appears on UdeM Nouvelles!
2025/03/14 – The lab makes its first big reagent order, gearing up for experiments!
2025/01/31 – Our collaboration with Sud Pinglay’s lab is published in Science. In a true sci-fi-like feat, Sud developed a way to shuffle mammalian genomes at scale! We served as technical assistance for the early design of the shuffle cassette, library prep, and performed scRNA-seq and clonotype mapping analyses.
2025/01/01 – The lab officially starts. After a long stay in milder climates, JB is pondering hibernating instead of braving a rough Montreal winter.
2024/12/23 – Great holiday gift before the time! JB is named an IVADO professor as part of the IA3 Apogée Canada grant. This will contribute to integrate the lab into a strong local machine learning and data science community.
